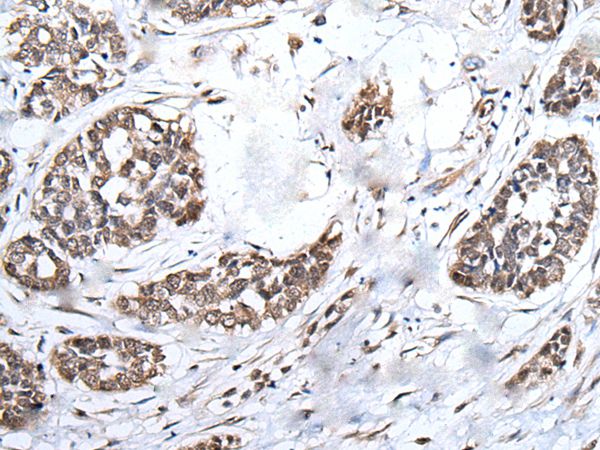

-
分类: 科研抗体货号: P43459别名: UAN; Su48; ZNF365D应用: WB,IHC反应种属: Human
-
分类: 科研抗体货号: P43461别名: BRMS1应用: IHC反应种属: Human
-
分类: 科研抗体货号: P43476别名: CC-1; CC-3; CKB1; MCIF; NCC2; SY14; HCC-1; HCC-3; NCC-2; SCYL2; SCYA14; HCC-1(1-74); HCC-1/HCC-3应用: WB,IHC反应种属: Human
-
分类: 科研抗体货号: P43458别名: KX; NA; NAC; X1k; XKR1; MCLDS应用: WB,IHC反应种属: Human
-
分类: 科研抗体货号: P43475别名: ATA1; NAT2; SAT1; SNAT1应用: WB,IHC反应种属: Human
-
分类: 科研抗体货号: P43456别名: HHGP应用: IHC反应种属: Human
-
分类: 科研抗体货号: P43472别名:应用: WB,IHC反应种属: Human
-
分类: 科研抗体货号: P43455别名: APS2; DIPP3a; DIPP3-alpha应用: WB,IHC反应种属: Human
-
分类: 科研抗体货号: P43471别名: PCL; FLT-4; FLT41; LMPH1A; VEGFR3; VEGFR-3应用: IHC反应种属: Human
-
分类: 科研抗体货号: P43454别名: CD299; LSIGN; CD209L; L-SIGN; DCSIGNR; HP10347; DC-SIGN2; DC-SIGNR应用: IHC反应种属: Human

鄂公网安备42018502007531号
鄂公网安备42018502007531号

